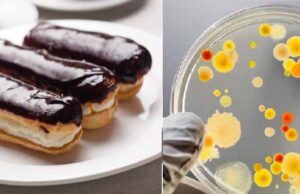
Закрили кав’ярню “Наше місто”, в якій 5 людей заразилися сальмонельозом Закрили кав’ярню "Наше місто"

admin
Нововолинці – за здоровий спосіб життя!
Є у Нововолинську люди, які сповідують здоровий образ життя. Їхній тренер Сергій Смолярук, або Smol, регулярно запрошує всіх на ранкову пробіжку. Збір о 6:00 кожної...
Над Нововолинськом пролетів торнадо! (Оновлено)
"На фото його ледве помітно, але насправді він був більш контрастним (трубу було помітно над хрестом цегляної церкви сьогодні біля 16:00)", - написав у...
Пограбували колишнього селищного голову
Серед білого дня, близько 7 години, грабіжники вдерлися у хату колишнього селищного голови -Володимира Рудя. Залізли, схоже, через вікно, так як воно було поламане,...
Як волинянам знайти інформацію про своїх предків
В сучасних умовах вільного доступу до інформації, кожен охочий може розпочати генеалогічні пошуки, не виходячи із дому. Світові інформаційні ресурси сьогодні є найпопулярнішим джерелом...
Про «таємниці» острова у Світязі відзняли відео
У мережі з'явився трейлер фільму жахів про острів на озері Світязь, - пише Район.ШацькКористувач Dooomaniya виклав не без гумору відзняте відео в YouTube під...
На Волині викрито організовану злочинну групу, яка за сприяння корумпованих митників...
Прокуратурою Волинської області спільно з Управлінням захисту економіки в області департаменту захисту економіки Національної поліції України у ході розслідування фактів протиправного ввезення на митну...
Польський телеканал проілюстрував “геноцид поляків” знімком українських жертв. 18+
Польський телеканал "Хісторія" проілюстрував допис про польських жертв УПА фотографією вбитих українців.
11 липня в Польщі вперше відзначали "Національний день пам’яті жертв геноициду громадян Другої...
Нововолинськ отримає 1.2 млн гривень на капремонт операційної та садочків
Кабінет Міністрів України виділив на розвиток міста Нововолинськ – 1,2 мільйони гривень. Ігор Гузь стверджує, що гроші для міста виділяються саме на його прохання. Із...
Кінотеатр “Україна” пішов з молотка за чотири з половиною мільйони гривень
14-го липня на аукціоні, який відбувся у приміщенні Нововолинської ради, кінотеатр “Україна” купив місцевий підприємець Юрій Сиротюк за 4 мільйони 692 тисячі гривень.
Cтартова ціна продажу становила...
На Західній Україні розшукують грабіжника, який спеціалізується на дітях!
На території Тернопільської області зареєстровано вже кілька випадків пограбування зловмисником дітей, у яких він забирає гроші і цінні речі. Рятуючись від переслідування правоохоронців зловмисник...
#позбавлення недоторканності: як голосував нардеп Ігор Гузь
Цього тижня у Генпрокурор України Юрій Луценко вніс шість (!) подань до Верховної Ради України щодо надання згоди на притягнення до кримінальної відповідальності народних...
Нечистоти біля 2 шахти зливає… водоканал!
Труба, з якої наподалік села Морозовичі гримуча суміш витікає просто в ґрунт, належить підприємству “Нововолинськводоканал”.
На околиці Нововолинська, в районі шахти №2, неочищені стоки зливаються просто...
Закрили кав’ярню “Наше місто”, в якій 5 людей заразилися сальмонельозом
Кав'ярня, в якій п'ятеро людей «підхопили» сальмонельоз, наразі не працює.
Про це інформує прес-служба Волинського обласного лабораторного центру.
П’ятеро осіб, в тому числі троє дітей 3,8 і 13 років...
Звернення Первинної профспілкової організації “Захист Праці” на ДП Шахта №1 “Нововолинська”...
«Завтра це вигадане правове беззаконня може бути застосований проти кожного з нас. Тому ми сьогодні повинні стати на захист
Богдана Макарчука».
Первинна профспілка «Захист...
Чорна рідина і страшенний сморід: хто зливає відходи біля Нововолинська?
Журналістка Юлія Ховайло неподалік від терикону другої шахти в Нововолинську виявила металеву трубу, з якої просто в грунт скидають смердючі відходи!"Підпільна" труба в районі...
Вибух, який чули у Нововолинську, пролунав від пробивання звукового бар’єру винищувачем
Близько години тому пролунав "вибух", який чули у Нововолинську та Володимирі-Волинському.У МНС пояснили, що над військовим полігоном у Володимирі-Волинському летів літак на низькій висоті,...
У Нововолинську закрили гральний заклад
Володимир-Волинська місцева прокуратура здійснює процесуальне керівництво досудовим розслідуванням у кримінальному провадженні за фактом незаконного заняття гральним бізнесом (кримінальне правопорушення, передбачене ч.1 ст. 203-2 КК України). Про це повідомляє прокуратура...
П’ятеро людей підхопили сальмонелу, з’ївши тістечка у кав’ярні
П’ятеро людей захворіли сальмонельозом після частування у кав’ярні. Про це стало відомо сьогодні, 11 липня, під час прес-конференції у Волинському обласному лабораторному центрі, -...
Флешмоб “Не Шанель №5”. А тобі “курчак” пахне на столі?
Журналісти “БУГу” відреагували на скарги щодо смороду, який поширюється від “Птахокомплексу “Губин”, і провели флеш-моб “Не Шанель №5”, до якого долучилися мешканці Нововолинська.Божевільний сморід...
На шахті №1 «Нововолинська» поліція та прокуратура проводять розслідування, допити та...
Слідчі національної поліції на чолі з прокурором другий день підряд проводять чергові розслідування, допити та обшуки на ДП шахті №1 «Нововолинська», - пише у...